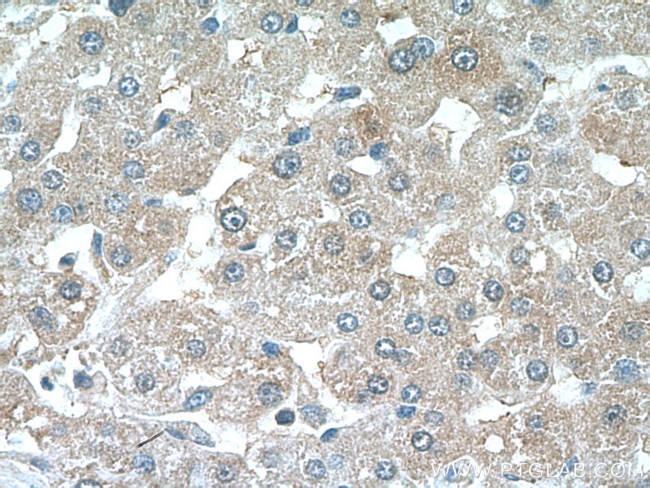
CRP Antibody in Immunohistochemistry (Paraffin) (IHC (P))

Search
Proteintech
CRP Polyclonal Antibody
{{$productOrderCtrl.translations['antibody.pdp.commerceCard.promotion.promotions']}}
{{$productOrderCtrl.translations['antibody.pdp.commerceCard.promotion.viewpromo']}}
{{$productOrderCtrl.translations['antibody.pdp.commerceCard.promotion.promocode']}}: {{promo.promoCode}} {{promo.promoTitle}} {{promo.promoDescription}}. {{$productOrderCtrl.translations['antibody.pdp.commerceCard.promotion.learnmore']}}
产品信息
24175-1-AP
种属反应
已发表种属
宿主/亚型
分类
类型
抗原
偶联物
形式
浓度
规格
纯化类型
保存液
内含物
保存条件
运输条件
产品详细信息
Immunogen sequence: QTDMSRKAF VFPKESDTSY VSLKAPLTKP LKAFTVCLHF YTELSSTRGY SIFSYATKRQ DNEILIFWSK DIGYSFTVGG SEILFEVPEV TVAPVHICTS WESASGIVEF WVDGKPRVRK SLKKGYTVGA EASIILGQEQ DSFGGNFEGS QSLVGDIGNV NMWDFVLSPD EINTIYLGGP FSPNVLNWRA LKYEVQGEVF TKPQLWP (19-224 aa encoded by BC125135)
靶标信息
CRP (C-reactive protein) is a major cyclic, pentameric acute phase protein compound consisting of five identical, noncovalently bound, nonglycosylated subunits. Eeach subunit is made up of 206 amino acids, and has a molecular weight of 24 kDa. CRP is produced by the liver, and its plasma levels rise dramatically during inflammatory processes occurring in the body. CRP is an initiator of classical complement cascade, binds to several nuclear components (chromatin, histones, etc.), plays an important role in innate immunity, and mediates activities associated with pre-immune nonspecific host resistance. Specifically, there is a 100-1000 fold increase of CRP in response to injury, infection or inflammation. CRP is opsonic, an initiator of the classical complement cascade, and an activator of monocytes/macrophages. CRP also binds to several nuclear components including chromatin, histones and snRNP, suggesting that it may play a role as a scavenger during cell necrosis. CRP is involved in several host defense related functions based on its ability to recognize foreign pathogens and damaged cells of the host, and initiates pathogen elimination by interacting with humoral and cellular effector systems in the blood. Patients with elevated basal levels of CRP have been shown to be an increased risk for hypertension and cardiovascular disease.
仅用于科研。不用于诊断过程。未经明确授权不得转售。
生物信息学
蛋白别名: c reactive; C-reactive protein; c-reactive protein coding sequence (partial); C-reactive protein precursor; C-reactive protein, pentraxin-related; C-reactive protein, petaxin related; CRP1; CSRP; CYRP; D1S181E; DKFZp686M148; DKFZp686M149; MGC149895; MGC88244; pentraxin 1; RP11-419N10.4; unnamed protein product
基因别名: AI255847; CRP; PTX1
UniProt ID: (Human) P02741, (Mouse) P14847
Entrez Gene ID: (Human) 1401, (Mouse) 12944